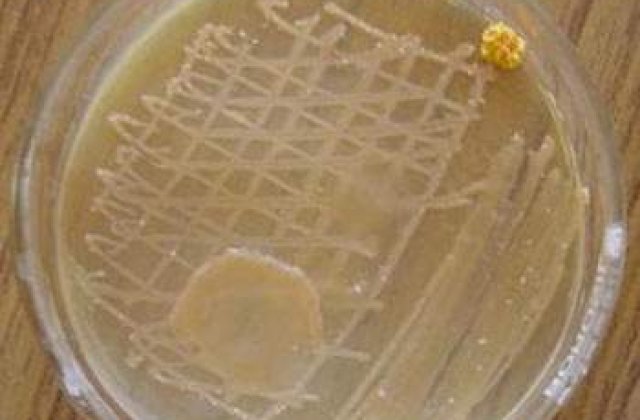
Cum trateaza germanii infectiile cu E.coli?

"Primele tratamente au fost incepute cu circa opt zile in urma", a anuntat Agentia franceza de securitate sanitara.
Laboratorul american Alexion, care a dezvoltat medicamentul Soliris (eculizumab), a refuzat sa comenteze informatia.
"Nu este nimic experimental; este o decizie luata in logica actualelor cunostinte stiintifice", a apreciat Chantal Loirat de la spitalul Robert Debre din Paris, adaugand ca "nu a vazut niciodata o epidemie de o asemenea gravitate".
Epidemia izbucnita in Germania este provocata de bacteria Escherichia coli enterohemoragica de un tip rar (E.coli O104:H4). Cea mai grava complicatie a bolii este sindromul hemolitic uremic (SHU), care este tratat in mod conventional cu transfuzii sau dializa, pentru compensarea deficientelor provocate de toxine.
Medicamentul Soliris dispune de o autorizatie europeana de punere pe piata din iunie 2007, fiind recomandat pentru pacientii care sufera de o boala rara (hemoglobinurie paroxistica nocturna), caracterizata prin episoade de distrugere a globulelor rosii.
"Este un medicament revolutionar pentru aceasta boala", a afirmat dr. Véronique Frémeaux-Bacchi, de la spitalul Georges Pompidou din Paris, conform MEDIAFAX.
In prezent, medicii germani evalueaza utilizarea medicamentului si la pacientii cu sindrom hemolitic uremic atipic, de origine infectioasa.
"Pentru aceste forme genetice, multe date sugereaza ca ar fi vorba despre un progres enorm. De circa un an, s-a pus problema utilizarii medicamentului pentru formele cele mai grave de sindrom hemolitic uremic (in special cu extensii neurologice), legate de infectarea cu E.coli enterohemoragica", a afirmat Loirat.
New England Journal of Medicine a publicat recent un studiu privind eficienta acestui medicament pentru formele foarte grave de SHU de origine bacteriana la trei copii din Franta, Canada si Germania.
Companie farmaceutică amendată cu 128,5 milioane de lei pentru...

"Este foarte dificil de dovedit ceva in cazuri izolate, dar, chiar si asa, cei trei copii riscau sa moara, dar au avut o evolutie favorabila", a adaugat Loirat.
Cei doi medici francezi afirma ca aspectele financiare legate de utilizarea medicamentului - Soliris a fost clasat drept cel mai scump medicament din lume, conform unui clasament realizat de Forbes in 2010 - nu pot fi luate in considerare. "Daca nu facem nimic, oamenii fie mor, fie raman cu handicap grav, fie raman dependenti de dializa", a afirmat Loirat.
Medicamentul este utilizat numai in spitale si necesita precautii de utilizare, inclusiv o vaccinare obligatorie prealabila tratamentului.
Despre autor:
Te-ar putea interesa si:
In lipsa unui acord scris din partea Internet Corp, puteti prelua maxim 500 de caractere din acest articol daca precizati sursa si daca inserati vizibil linkul articolului.
Mai multe despre
-

Ce planuri are PKO Bank în România: cea mai mare bancă din Polonia are active...
Sursa: futurebanking.ro
-

Sumă record cheltuită de utilizatorii OnlyFans în 2024. Câți bani au ajuns la...
Sursa: wall-street.ro
-

ANALIZĂ VIDEO Primele produse tehnologice sunt mai mereu proaste
Sursa: start-up.ro
-

Paște 2026: cât costă un cozonac plin cu de toate, în București
Sursa: retail.ro
-

Cine sunt speakerii Green Forum 2026: Cum finanțăm?
Sursa: green.start-up.ro
-

Hollywood-ul este în alertă! Actor celebru, găsit înjunghiat în fața locuinței
Sursa: kudika.ro
-

Horoscop bani săptămâna 8-14 iunie: Venus în Rac îți deschide portofelul!...
Sursa: garbo.ro